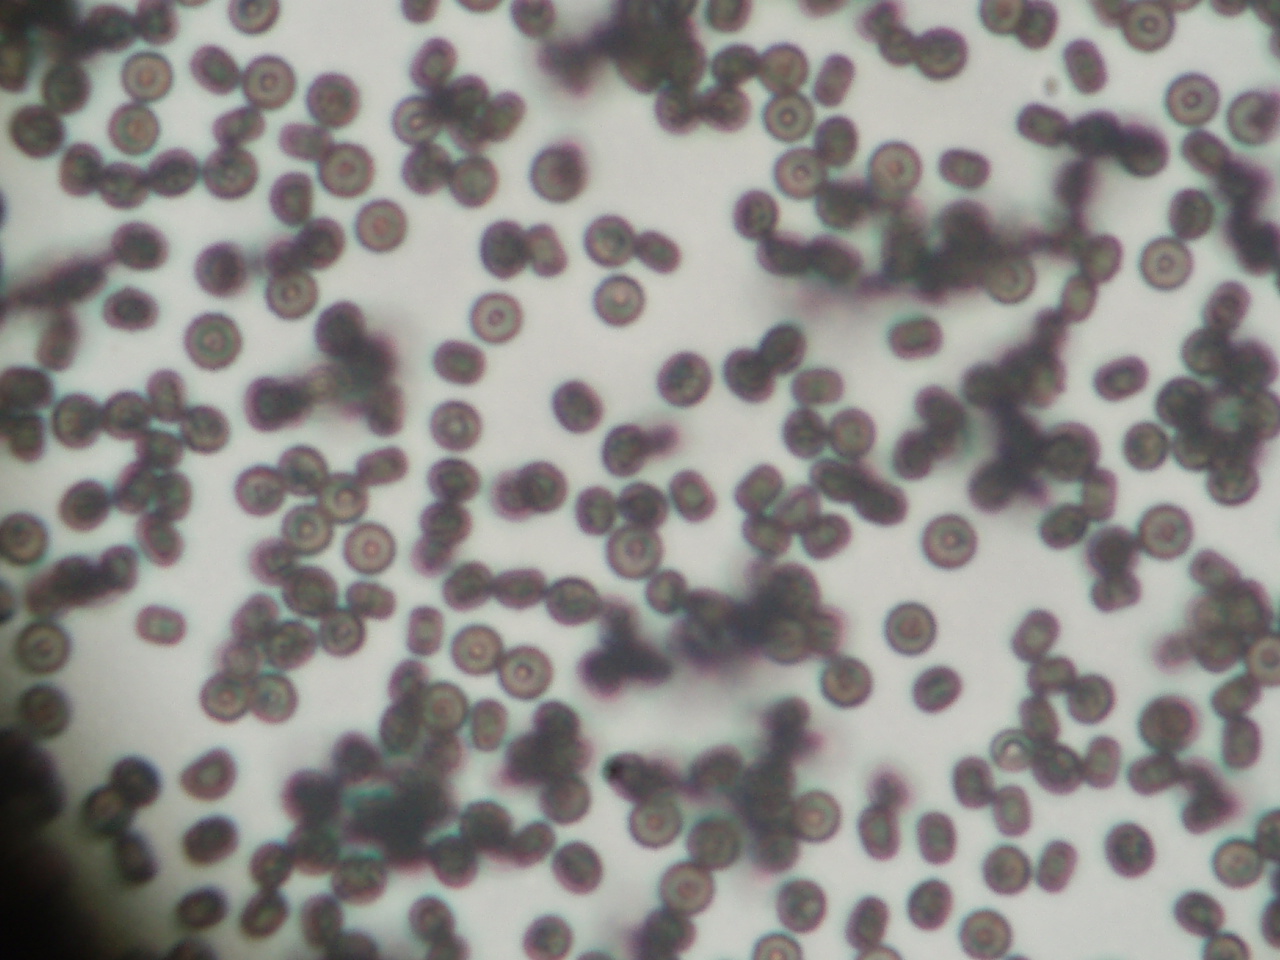
本日のカビ Sunny Style

カビ ルンルン 画像
カビ ルンルン 画像. 杉並区阿佐ヶ谷の形成外科・皮膚科専門医 稲葉クリニックのトップページへ 稲葉クリニックのご案内へ 皮膚病(皮膚の病気) 目次 へ戻る 皮膚病(皮膚の病気) 2 (杉並区の皮膚科から) 真菌・虫による皮膚病の症状(写真画像) 原因と治療・注意点などにつきまして簡単にまとめてあり. カビルンルン 画像数:31枚中 ⁄ 1ページ目 更新 プリ画像には、カビルンルンの画像が31枚 あります。.
本日のカビ Sunny Style from blog.livedoor.jp
本日のカビ Sunny Style from blog.livedoor.jp
カビルンルン 画像数:31枚中 ⁄ 3ページ目 更新 プリ画像には、カビルンルンの画像が31枚 あります。. アンパンマン カビルンルン 画像数:19枚中 ⁄ 1ページ目 更新 プリ画像には、アンパンマン カビルンルンの画像が19枚 あります。 一緒に おさるのジョージ 、 ペンギン イラスト 、 さとみ 背景透過 、 韓国 、 女の子 イラスト おしゃれ も検索さ. カビルンルン 血液型 a 出身地 愛知県 最新の記事 お風呂場の隅 言葉通りだった何か足りねーよ テーマ: ブログ 11年07月日 18時38分 15 10 ハヒヘホ テーマ: ブログ 11年06月24日 23時28分 5 柔軟性あるヒューマニズムまたぐリズム繋ぐ韻から韻 蝶のようなライミングを披露.
カビルンルン 血液型 a 出身地 愛知県 最新の記事 お風呂場の隅 言葉通りだった何か足りねーよ テーマ: ブログ 11年07月日 18時38分 15 10 ハヒヘホ テーマ: ブログ 11年06月24日 23時28分 5 柔軟性あるヒューマニズムまたぐリズム繋ぐ韻から韻 蝶のようなライミングを披露.
カビは湿度が高いと生えやすいイメージがありますが湿度が比較的低い環境を好むカビもいます。多くのカビは 湿度70%以上 で 温度は0~45℃ (特に~40℃)、それに加えてカビのエサとなる栄養分と適量の酸素があるとカビが発生します。それぞれのカビ. ルンルン??? リアルにカビルンルン そして、父も今日から仕事に戻りました 母にとってはかなり幸せだった日々が終わってしまった 朝もゆっくり過ごせたし、一人でご飯食べることもなく 今週はお弁当無しでいいらしいので、5. カビの種類は何万種類も さらに毎年新種が発見され増えていっています。 しかし、日本の家庭で見かける主なカビは種類もありません。意外と少ないですよね。カビの種類は数多くありますがすべての種類を知る必要はありません。 こ. カビルンルンの画像31点 2ページ目 完全無料画像検索のプリ画像 Bygmo カビルンルン 画像 素材 カビルンルン 画像 素材バイキンカレーパンマン בטוויטר 昔から今までやはりカビルンルンは最強だね メルカリ カビルンルン キャラクターグッズ 8 中古や未使用のフリマ 楽天市場 カビ.
カビ ルンルン 画像 のギャラリー




